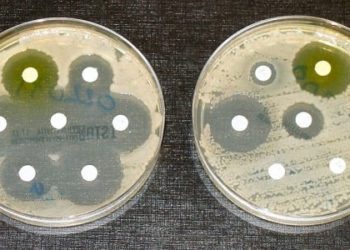
Antibiotic misconceptions persist in Medicaid-insured parents

The EMPACTA trial: Tocilizumab reduced COVID-19 disease-related adverse health outcomes [Classics Series]
This study summary is an excerpt from the book 2 Minute Medicine’s The Classics in Medicine: Summaries of the Landmark Trials
1. Tocilizumab reduced the need for mechanical ventilation and lowered death outcomes in patients infected with severe acute respiratory syndrome coronavirus 2 (SARS-CoV-2).
2. Treatment with tocilizumab did not improve survival among patients.
Original Date of Publication: December 2020
Study Rundown: Cases pertaining to the coronavirus disease 2019 (COVID-19) have led to severe clinical manifestations requiring mechanical ventilation. However, fatal outcomes have still resulted despite currently treatments and supportive care. This trial investigated the safety and efficacy of tocilizumab, an anti-interleukin-6 receptor monoclonal antibody, in patients hospitalized with COVID-19 pneumonia. These hospitalized patients were randomly assigned into one of two groups after informed consent was obtained. Patients were followed for two months and outcomes such as the need for mechanical ventilation or death were assessed on day 28. The trial results displayed both the efficacy and safety of tocilizumab treatment in managing patients with COVID-19 pneumonia. However, both groups revealed similar death outcomes. The study was strengthened by its focus on the inclusion of ethnic and racial minority patients. Conversely, the study was limited by the short follow-up period. Nonetheless, the study results are important as they showed tocilizumab reduces adverse health outcomes related to COVID-19.
Click to read the study in NEJM
In-Depth [randomized control trial]: This phase 3, double-blind trial enrolled 389 participants across multiple countries including Brazil, Kenya, Mexico, Peru, South Africa, and the United States. This study enrolled patients over the age of 18 with confirmed COVID-19 pneumonia who were hospitalized. Patients were excluded if they required additional breathing assistance such as continuous positive airway pressure, mechanical ventilation, or bilevel positive airway pressure. Patients were randomized in a 2:1 ratio to the standard of care including one or two doses of either tocilizumab or a placebo, respectively. On day 28, the primary endpoint of mechanical ventilation or death was evaluated for all participants. The results were further investigated using analysis and stratification, where the median follow-up time was 60 days.
By day 28, an overall of 12% (95%CI 8.5-16.9%) of the patients in the tocilizumab group had either received some form of mechanical ventilation or had died, whereas a total of 19.3% (95% CI 13.3-27.4%) of the placebo group had experienced these outcomes. The hazard ratio for mechanical ventilation or death between both groups was 0.56 (95%CI 0.33-0.97 p = 0.04). Furthermore, 15.2% of the patients reported serious adverse events in the study drug group compared to 19.7% were reported in the placebo. Consequently, more deaths were reported in the placebo group (29 patients) compared to the tocilizumab group (15 patients), although all-cause mortality at 28 days did not differ significantly between the two groups (weight difference 2.0; 95%CI −5.2 to 7.8). Overall, these findings demonstrate that tocilizumab is both safe and effective in treating patients with COVID-19 pneumonia.
Salama C, Han J, Yau L, Reiss WG, Kramer B, Neidhart JD, et al. Tocilizumab in Patients Hospitalized with COVID-19 Pneumonia. N Engl J Med. 2021 Jan 7;384(1):20–30.
©2022 2 Minute Medicine, Inc. All rights reserved. No works may be reproduced without expressed written consent from 2 Minute Medicine, Inc. Inquire about licensing here. No article should be construed as medical advice and is not intended as such by the authors or by 2 Minute Medicine, Inc.